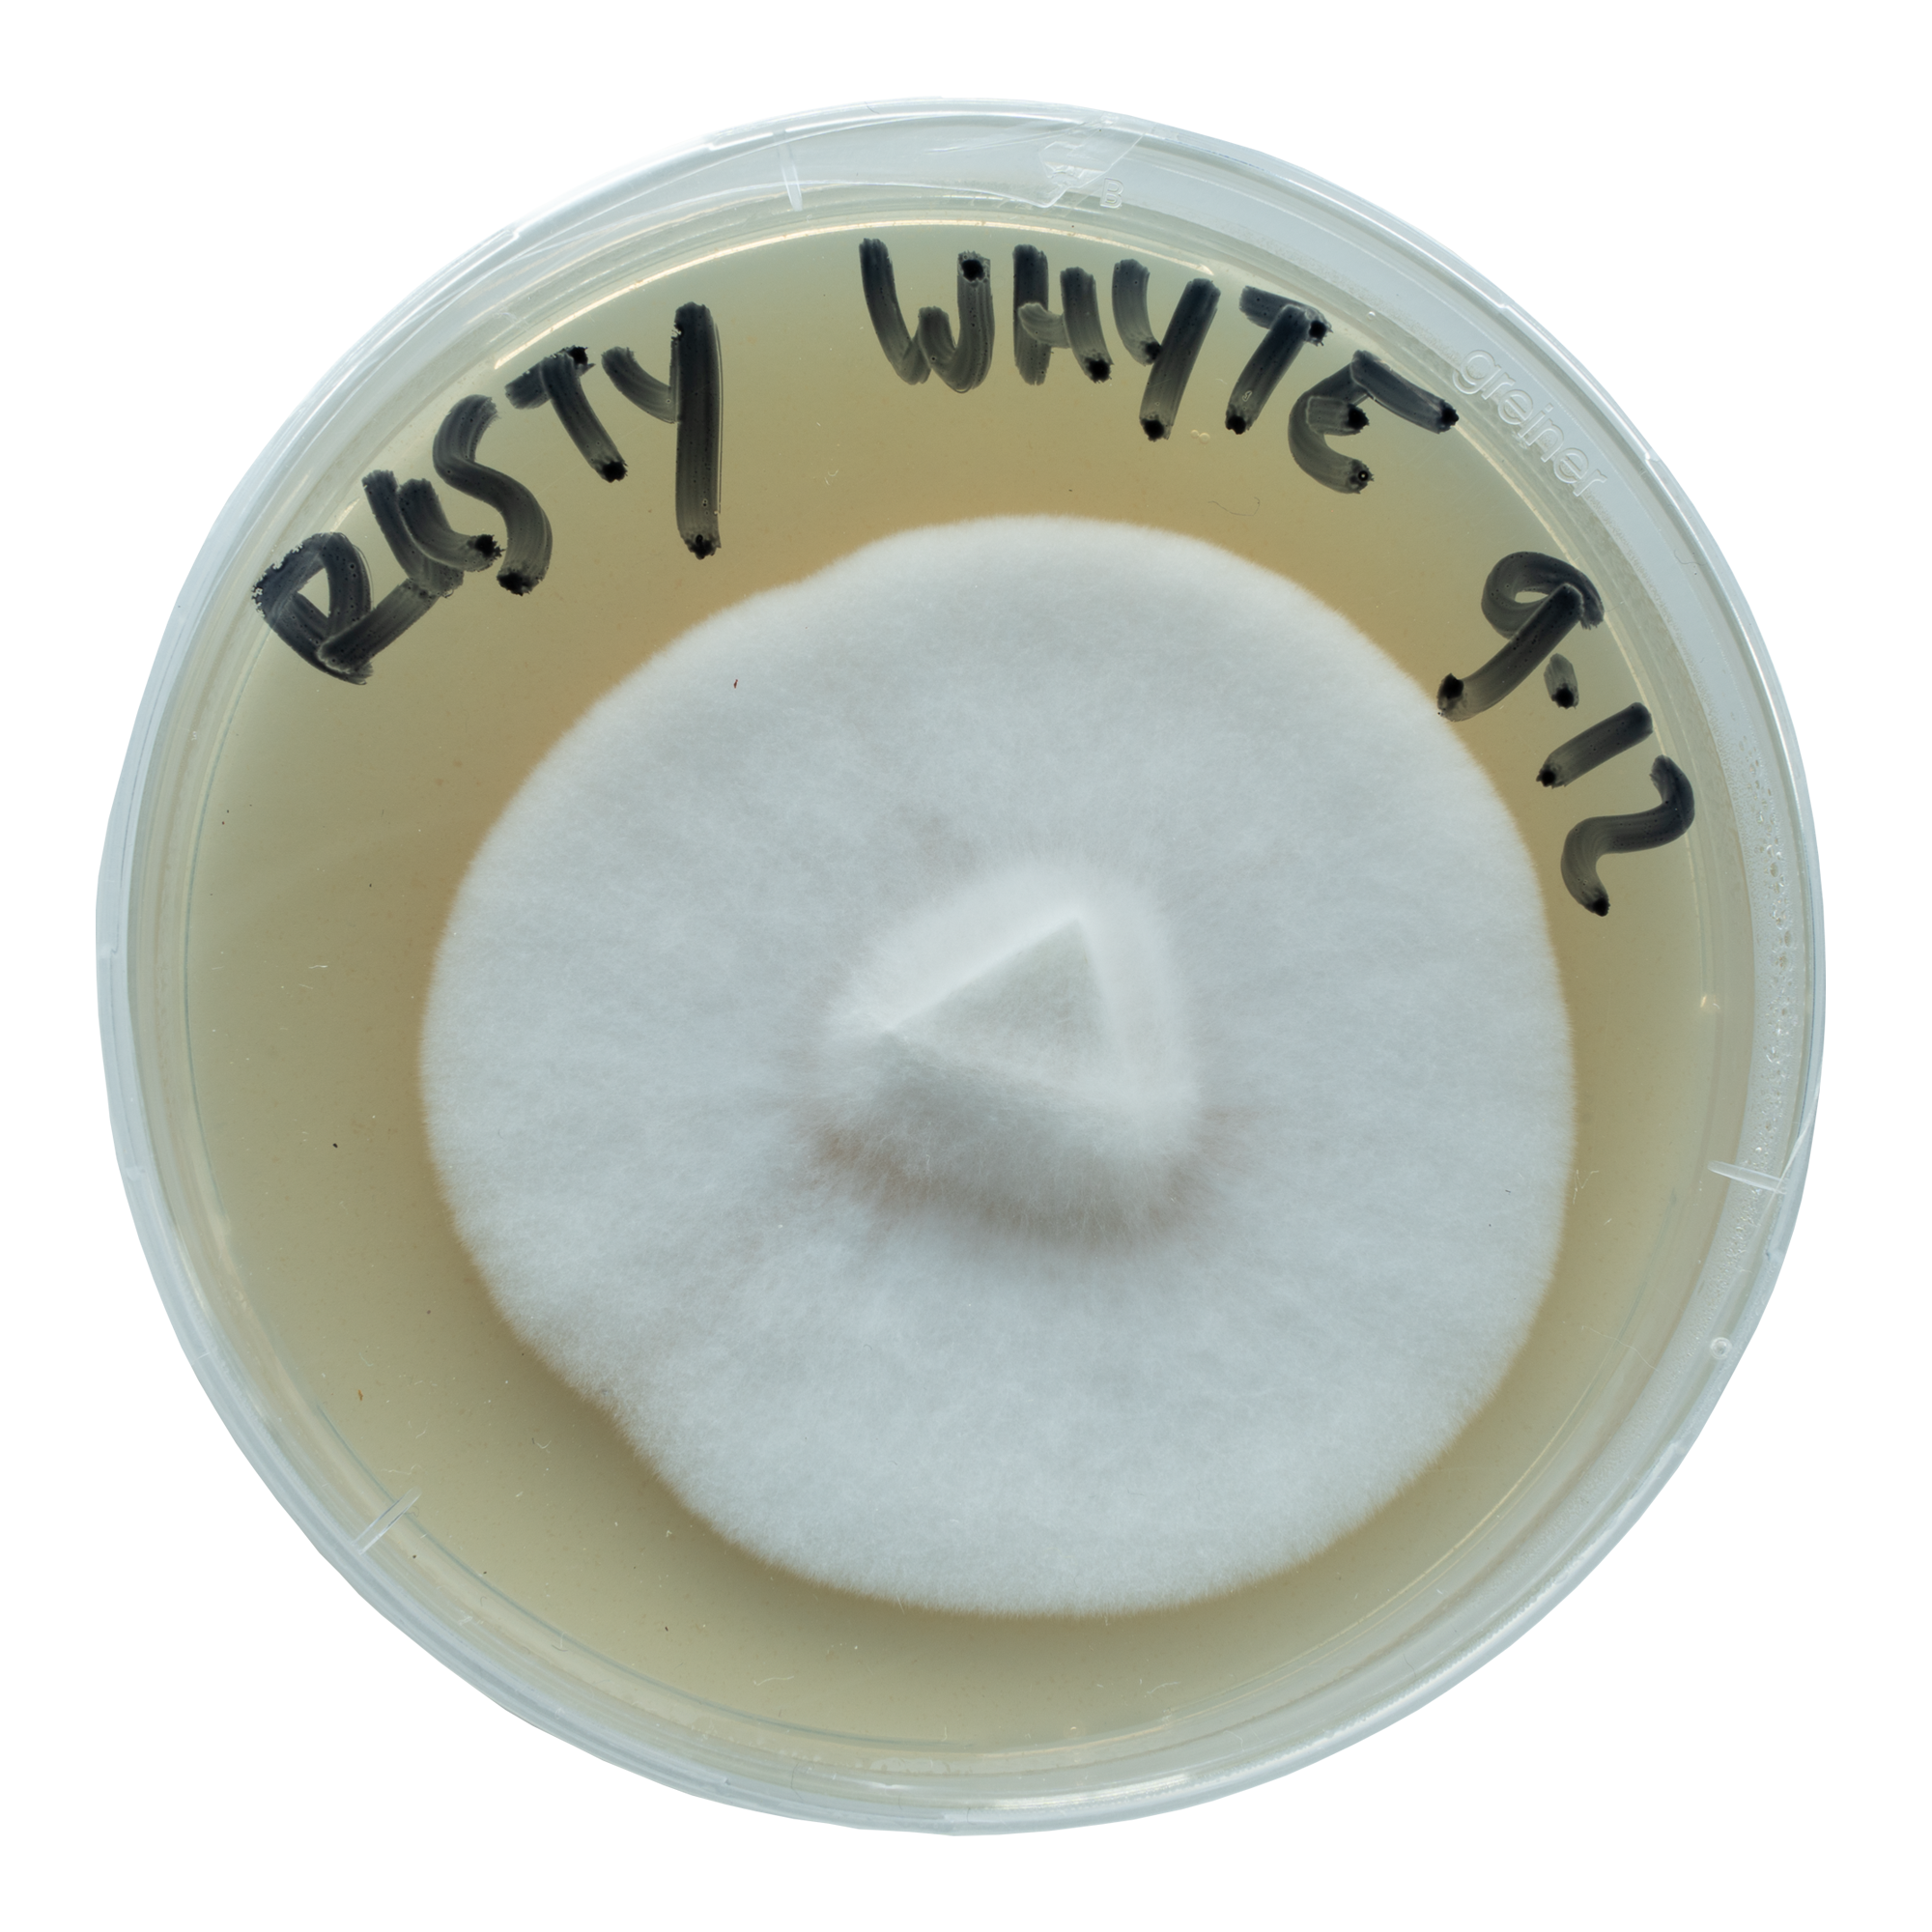

Rusty Whyte Zauberpilze: Ursprünge und Genetik
Rusty Whyte, auch bekannt als Rusty White, ist eine Psilocybe cubensis-Sorte, die von PastyWhyte, einem langjährigen Shroomery-Nutzer und Hobby-Mykologen aus Kanada, entwickelt wurde. Das Projekt begann 2014, als Pastywhyte Albino A+ (AA+) und Colombian Rust (CRS) Sporen auf einer Agarplatte kombinierte. Mit der Zeit stabilisierte er die Genetik durch mehrfaches Wachsen und Sporenabdrücke, was zu der Rusty Whyte-Sorte führte, die wir heute kennen.
Nachdem er die Sorte stabilisiert hatte, teilte Pastywhyte Sporenabdrücke mit anderen Shroomery-Mitgliedern, damit sie die neue Sorte selbst ausprobieren konnten. Schließlich produzierten diese Grows weitere Sporenabdrücke, die in der Community verteilt wurden, was dazu führte, dass die Sorte weithin verfügbar und beliebt wurde.
Die Zauberpilze von Rusty Whyte sind leucistisch, was bedeutet, dass sie normalerweise geisterhaft weiß bis hellgelb aussehen, je nachdem, wie viel Licht sie ausgesetzt sind. Außerdem produzieren sie rostfarbene Sporen, ein Merkmal der Colombian Rust-Genetik.
Acid Shroomz Rusty Whyte Flüssigkultur Entwicklung
Wir begannen die Entwicklung unserer Rusty Whyte-Flüssigkultur mit einem hochwertigen Rusty Whyte-Sporenabdruck, von dem wir Sporen auf mehrere Agarplatten schabten. Sobald die Sporen gekeimt waren, wählten wir gesunde Abschnitte des Myzels aus und übertrugen sie auf ein Getreidesubstrat, um ihre Fruchtbarkeit zu testen.
Aus den so entstandenen Pilzen klonten wir ein vielversprechendes Exemplar und verfeinerten es in mehreren Runden durch Subkulturen, bis wir schließlich eine robuste Monokultur hatten. Die endgültige Monokultur wurde gründlichen Leistungstests unterzogen, und als wir mit den Ergebnissen zufrieden waren, haben wir sie als Grundlage für unsere Flüssigkulturproduktion verwendet.
Die daraus resultierende Sorte Rusty Whyte ist aggressiv, schnell wachsend und sehr widerstandsfähig gegen Verunreinigungen, was sie für Anbauer aller Erfahrungsstufen geeignet macht. Sie produziert leuchtende, schwach pigmentierte Pilze mit rostfarbenen Kiemen und Sporen, die in der Regel mehrere Flushes hervorbringen und eine durchschnittliche Potenz aufweisen – ideal für einen beständigen und zuverlässigen Anbau.
Produktinhalt
Jede Rusty Whyte-Spritze enthält 20 ml lebendes Myzel in einer sorgfältig formulierten Nährstofflösung. Die Spritze ist ein hochwertiges B. Braun-Modell für eine präzise Handhabung und Inokulation.
Außerdem enthält die Produktverpackung zwei Tücher mit 70%igem Isopropylalkohol, eine sterile 16G-Spritzennadel und einen Beipackzettel.
Wie man eine Rusty Whyte Flüssigkultur-Spritze benutzt
Weitere Informationen findest du in unseren Artikeln zur Verwendung von Flüssigkultur-Spritzen.
Sicherheitsvorkehrungen und Handhabung
Beim Umgang mit der Rusty Whyte Flüssigkultur-Spritze ist es wichtig, die richtigen Sicherheitsvorkehrungen zu treffen, um Verunreinigungen zu vermeiden und einen erfolgreichen Wachstumsprozess zu gewährleisten. Hier sind einige allgemeine Richtlinien, die du beachten solltest:
- Handle die Spritze immer in einer sauberen und sterilen Umgebung.
- Trage puderfreie Nitrilhandschuhe und eine Gesichtsmaske, um eine Kontamination zu vermeiden.
- Achte darauf, dass an deinem Arbeitsplatz wenig bis gar keine Luftströmung vorhanden ist.
- Vermeide es, die Nadel oder die Flüssigkultur direkt zu berühren, um die Sterilität zu erhalten.
- Lagere die Spritze im Kühlschrank bei 4-7°C, um ihre Haltbarkeit zu verlängern.
Optionales Zubehör
Verwende für zusätzliche Sterilität während der Beimpfung von Substraten eine Laminar-Flow-Haube oder eine Still-Air-Box (SAB).
Allgemeine Daten
| Arten | Psilocybe cubensis |
| Genetik | Albino A+ X Columbian Rust |
| Sporen | Rostfarbene Sporen |
| Anwendungen | Für die Mikroskopie, Forschung und Taxonomie. |
| Schwierigkeitsgrad | Anfänger |
| Geschwindigkeit der Kolonisierung | Schnell |
| Potenz | Mittel |
Anbaudaten
| Laichphase | |
| Geeignete Substrate | Sterilisierte Körner wie Naturreis, Roggen, Hafer, Hirse, Popcorn oder Wildvogelfutter. |
| Besiedelungszeit | 9-14 Tage (2/3 gefülltes Literglas / 27°C / geschüttelt bei 25-33% Besiedlung). |
| Temperatur | 25-27°C |
| Licht | Wenig Licht oder Dunkelheit. |
| Fruchtbare Phase | |
| Geeignete Substrate | Dung, Kokosfaser, CVG oder Stroh (ausreichend hydriert und wärmebehandelt). |
| Temperatur | 21-25°C |
| Relative Luftfeuchtigkeit | 80-100% |
| Frischluftaustausch (FAE) | Sorge für eine gute Luftzirkulation, ohne dass das Substrat austrocknet. |
| Licht | Indirektes Tageslicht oder weiches Kunstlicht (etwa 6500 Kelvin). |
Anmerkungen
Dieses Produkt hat eine begrenzte Haltbarkeitsdauer und kann nicht zurückgegeben werden. Weitere Informationen findest du auf unserer Seite zu Bedenkzeit und Rückgabe.

Bewertungen
Es gibt noch keine Rezensionen